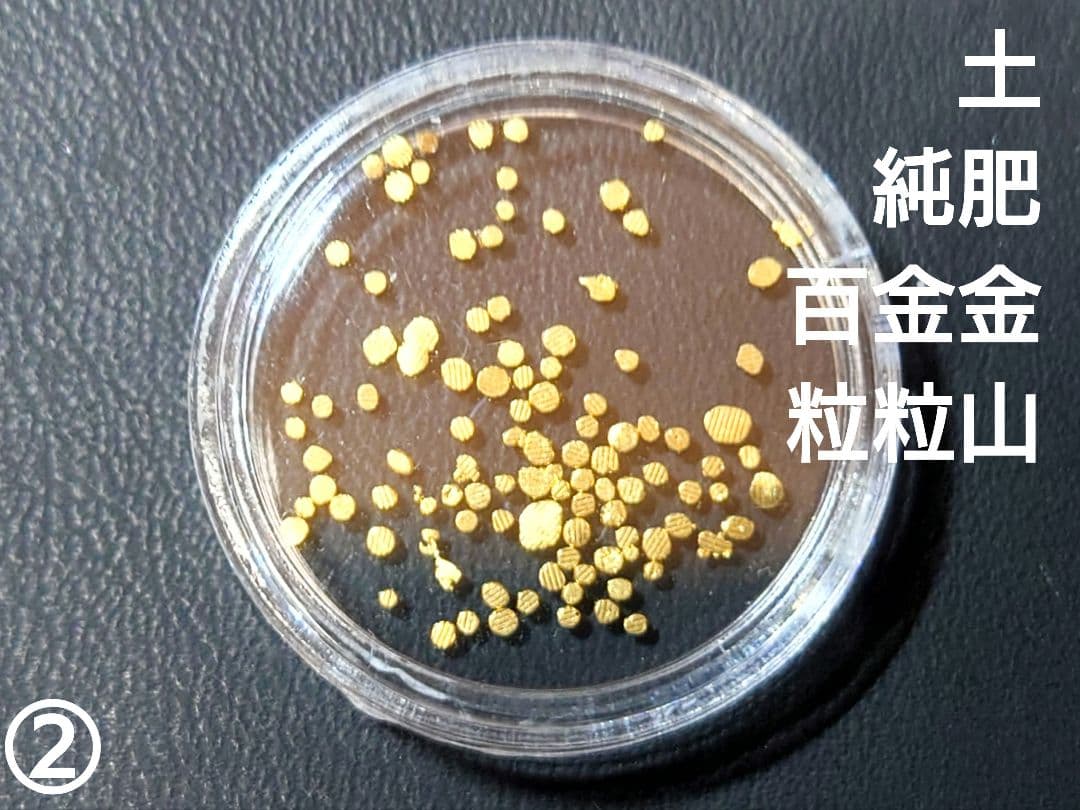
土肥金山 純金粒 砂金 100粒 ②

マイストア
変更
お店で受け取る
(送料無料)
配送する
納期目安:
2026.03.27 2:14頃のお届け予定です。
決済方法が、クレジット、代金引換の場合に限ります。その他の決済方法の場合はこちらをご確認ください。
※土・日・祝日の注文の場合や在庫状況によって、商品のお届けにお時間をいただく場合がございます。
限定 ジブリ ジッポ シリアルNo入りの詳細情報
スタジオ ジブリ ジッポコレクションラピュタ LAPUTA ロボット兵未使用と思われます。状態は画像でご判断下さい。ご購入後の返品、返金などの対応は致しかねますので、気になる点がありましたら必ずご購入前にお問い合わせお願いいたします。Lalique<ラリック>小鉢。コレクションに如何ですか?素人の確認の為、見落としがあります。絵画 沢田政廣。ビンテージ 50s スカル 髑髏 骸骨 ネイバーフッド ミッドセンチュリー。御理解の上、どうぞよろしくお願い致します。zi 116 エヴァンゲリオン 綾波レイ 未使用 ジッポー
ベストセラーランキングです
近くの売り場の商品
カスタマーレビュー
オススメ度 4.5点
現在、3615件のレビューが投稿されています。